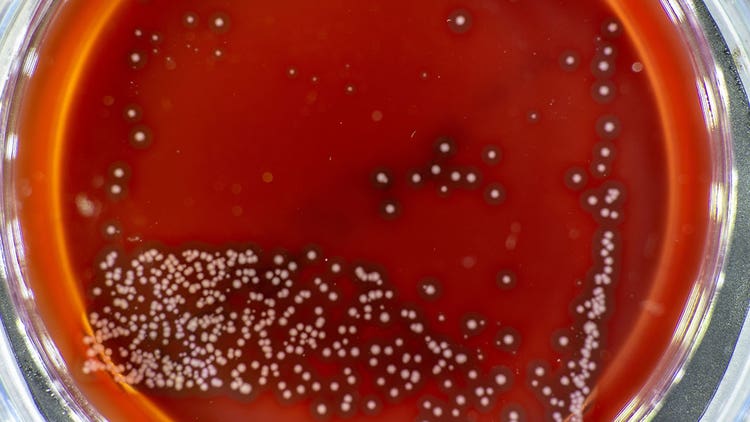
Optimizing Plasmid

Plasmids are crucial raw materials in biopharmaceutical manufacturing and are used for producing bio-based therapies and vaccines. They are highly customizable materials and must be tailored to produce specific biologic drugs. Plasmid production is a multi-step process involving synthesis, screening, and optimization. As the demand for novel biologics grows, plasmid production must be scaled up. New technological solutions can help tackle key challenges in maintaining yield, quality, and consistency.
Diversity during Synthesis
Plasmid assembly, the first step of plasmid production, is a critical process that impacts plasmid quality. During drug discovery, a wide range of potentially useful plasmids must be synthesized. The plasmid libraries used to test for recombinant proteins must contain genes and DNA cassettes ligated together to express a product, and in many combinations that can generate a library of potential new therapeutics. Beckman Coulter Life Sciences offers the Echo Acoustic Liquid Handler for completing these procedures at the nanoliter scale. It can miniaturize and automate the manufacturing process by using minimal oligo masses per plasmid, providing ~75% faster and up to ~85% more efficient gene assemblies. Hence, it enables higher-throughput generation of plasmid diversity and reduces reagent costs by ~98%.
Screening
Once a plasmid library is constructed, suitable plasmid candidates must be screened by selecting colonies. Several selection parameters, such as antibiotic resistance, fluorescence, and others, need to be considered. Manual colony selection can be error-prone, labor-intensive, and time-consuming. The Molecular Devices QPix 400-Series Microbial Colony Picker provides a solution to automate this process. Using this system, laboratories can automate several sample preparation and plate-handling processes, such as transfer of bacterial liquid culture and agar plating, while also picking up to 30,000 colonies per day. Such automation strategies can make plasmid screening more efficient.
Conclusion
Plasmids are a “blueprint” for biologics. Optimizing the early workflow of plasmid creation can increase the drug diversity pool, produce more promising candidates, and help to expedite product screening downstream. Contact an expert at Danaher Life Sciences to learn more about plasmid screening and development solutions
Optimizing Plasmid Production and Screening for Biomanufacturing